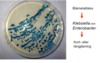

Urinvägsinfektion Flashcards
Urinvägsinfektion
- vanligt?
- vad för sorts infektion?

Vad pekar pilarna på vid bilden?


Klassificering Praktisk indelning av UVI för att optimera diagnostik, behandling och utredning, förklara indelningen

Förklara orden på bilden?


Epidemiologi
- drabbar vilka mest?

Urinvägspatogener
Spridning sker från tarmfloran till urinvägarna
- Samspelet mellan värd och mikrob avgör om infektion ska uppstå och även på den kliniska svårighetsgraden
- Normala urinvägar –hög bakterievirulens krävs för UVI
- KAD eller residualurin–lågpatogena bakterier kan ge allvarlig UVI
UVI skillnad mellan kvinnor ocxh män ?
>> Kvinnor med recidiverande UVI har ofta störningar i vaginala mikrobfloran
>>Män får ej ofta UVI pga urinröret är långt från perianala området samt skyddande baktericida ämnen från prostata.
Vad gör primärpatogener?
Primärpatogener: orsakar UVI hos individer med normala urinvägar
- E.coli(70-90%)
- Staphylococcus saprophyticus (5-30%)
Vad gör sekundärpatogener?
Sekundärpatogener:
betydelse vid recidiv UVI och vid nosokomialUVI samt vid komplicerad UVI (strukturella/funktionella avvikelser i urinvägarna)
Klebsiella, Enterobacter, Proteus, Pseudomonas, Enterococcusmfl
Vilken är den vanligaste orsaken till UVI?
- Tillhör familjen Enterobacterieceae
- Vanligasteorsaken till UVI, tillhör normalflorai tarmen
- Virulensfaktorersåsom fimbrier, kapsel, LPS (endotoxin)
Vilken är den näst vanligaste orsaken till UVI?
Staphylococcus saprophyticus
Den näst vanligaste urinvägspatogenen i primärvården, drabbar kvinnor i fertil ålder
Vilket är vanligaste hos kvinnor?
S. Saprophyticusär vanligast hos unga kvinnor
Akut cystit –blåskatarr, symptom?
- Dysuri–brännande sveda vid vattenkastning
- Obehag eller värk ovan symfysen(blygdbenet)
- Täta trängningar
- Kissar ofta, små volymer
- Ofta grumlig, illaluktande urin
- Sällan feber(barn feber ibland)
Vad är Pyelonefrit-njurinflammation?
potentiellt allvarligt tillstånd, kan leda till bakteriemioch bestående njurskador
- Börjar ofta som en cystit
- Påverkat allmäntillstånd, sjukdomskänsla, huvudvärk, flanksmärtor, smärtor över njurarna
- Oftast feber 38 –40°C
Asymtomatisk bakteriuri(ABU)
- Allmänhet lågvirulenta bakterier
- Kan utgör skydd mot invasion av mer virulenta bakterier
- Oftast godartat, ingen antibiotikabehandling
MEN
- Gravida med ABUbehandlas eftersom hormonella omställning och livmodertillväxt ökar risken för akut pyelonefrit.
Behöver man ta urinodling vid misstanke om UVI?
Behövs Ej vid misstanke om okomplicerad nedre UVI hos tidigare frisk kvinna
- Alltidvid misstanke om:
- Febril UVI
- UVI hos män
- UVI hos gravida
- UVI hos barn
- UVI hos inneliggande patiente
Hur ska en bra urinprovtaging gå till?

Hur sker urinprovtagning med blöjbarn och barn under 1 år?

Hur sker urinprovtagning av KAD?

Hur fungerar urinsticka?

Man mäter även CRP och S-kreatinin, varför mäter man dem och vad ska de ligga på?
- CRP (i serum):
Cystit <30 mg/l
Pyelonefrit ≥30 mg/l
(Obs: vid tidig pyelonefrit har ej CRP-nivån ökat)
- s-kreatinin
Markör för njurens glomerulära filtration(dvs pyelonefrit)
Vad görs på laboratoriets med urinprover?
- Utodling av urinprov:
- artbestämning
- kvantifiering
- resistensbestämning
- Semikvantitativ odling:
en bestämd mängd urin (10ml) sätts till olika agarplattor
Identifiering av olika bakterier?
Koloniutseende:
utseende på olika medierstorlek, färg, form, konsistens, lukt
Gram-färgning:
Gram-positiv eller Gram-negativ, stav eller kock, enstaka, kedjor, klasar
Biokemiskatester:
fermentering av kolhydrater ”jäsning”bakteriella enzymerantibiotikakänslighet
Identifiering av E.coli?